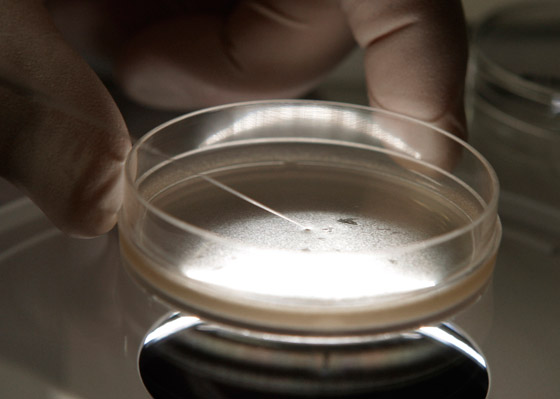
اختراق علمي مذهل وخوف على البشر: أجنة بشرية اصطناعية تثير الجدل! صورة رقم 5

نجح العلماء في تخليق أجنة بشرية اصطناعية باستخدام الخلايا الجذعية، وذلك في إنجازٍ علمي رائد يُلغي الحاجة إلى البويضات والحيوانات المنوية. ويقول العلماء إن هذه الأجنة النموذجية تُشبه الأجنة في المراحل الأولى من النمو البشري، حسب ما ذكرته صحيفة بريطانية، الأربعاء.
قد تمنحنا هذه الأجنة نافذة مهمة على آثار الاضطرابات الوراثية، وكذلك الأسباب البيولوجية للإجهاض المتكرر. لكن عمل هؤلاء العلماء يثير بعض المسائل الأخلاقية والقانونية الخطيرة أيضاً، لأن الكائنات المُخلّقة في المختبر تقع خارج نطاق التشريعات القائمة في المملكة المتحدة وغالبية الدول. حسب التقرير، لا تحتوي تلك التكوينات على قلبٍ نابض أو شكلٍ أولي للدماغ. لكنها تحتوي على الخلايا التي من المعتاد أن تنمو لتُشكل المشيمة، والكيس المحي، والجنين نفسه.

وصفت أستاذة جامعة كاليفورنيا ومعهد كاليفورنيا للتقنية، ماغدالينا زرنيكا-غيوتز، هذا العمل في خطاب أدلت به على هامش اللقاء السنوي للجمعية الدولية لأبحاث الخلايا الجذعية في بوسطن، وقالت: "نستطيع تخليق نماذج تشبه الأجنة عن طريق إعادة برمجة الخلايا الجذعية الجنينية". لكن ليست هناك احتمالية لاستخدام أجنة بشرية اصطناعية سريرياً على المدى القريب، حيث سيكون من غير القانوني زراعتها داخل أرحام المريضات، ولم يتضح بعدُ ما إذا كانت تلك التكوينات قادرةً على مواصلة النضج بعد مراحل النمو الأولى أم لا.
فقال باحثون أميركيون وبريطانيون إنهم ابتكروا أول هياكل شبيهة بالأجنة البشرية الاصطناعية في العالم من الخلايا الجذعية، متجاوزين الحاجة إلى البويضات والحيوانات المنوية. وفي زمن يبدو فيه العلم قادرا على تجاوز كل الحدود، جاء هذا الاختراق ليثير الآمال والخوف بنفس المقدار ربما. الاختراق العلمي الذي سجل نتيجة تعاون بين جامعة كامبريدج ومعهد ماساتشوستس للتكونولوجيا يوحي باقتراب قدرة الإنسان على تحقيق ولادة كائن بشري دون الحاجة إلى حيوان منوي أو حتى إلى بويضة.

"أجنة نموذجية اصطناعية".. هكذا سميت هذه الأجنة التي استولدت من الخلايا الجذعية، وهي تشبه تلك الموجودة في المراحل الأولى من التطور البشري، وبينما يتباهى العلماء بأن الاختراق يمكن أن يساعد في البحث في الاضطرابات الوراثية، فإن هذا الإنجاز يثير قضايا أخلاقية وقانونية، فضلا عن مقدار من الخوف على مستقبل البشر.
فالأجنة التي نمت في المختبر لا تحتوي على قلب ينبض أو حتى بدايات دماغ، ولكنها تشتمل على خلايا تتطور عادةً إلى مشيمة وكيس محي الجنين نفسه، لكن ليس من الواضح بعد ما إذا كانت لدى تلك الأجنة القدرة على الاستمرار في النضج بعد هذه المرحلة، أو حتى النمو داخل كائن حي، مما يؤدي في النهاية إلى الحمل. وقد سبق أن أجريت تجربة الأجنة على إناث القرود والفئران لكن لم ينتج عن أي منها حمل. ويُسمح للعلماء حاليًا بزراعة الأجنة فقط في المختبر حتى الحد القانوني البالغ 14 يومًا، وسيكون من غير القانوني زرعها في رحم المريض حتى الآن.

هدف خلق أجنة بشرية اصطناعية
ينبع الدافع وراء خلق أجنة بشرية اصطناعية من رغبة العلماء في فهم فترة "الصندوق الأسود" الخاصة بالنمو. ويُطلق هذا الاسم على تلك الفترة، لأن العلماء يستطيعون رعاية الأجنة في المختبر لمدة 14 يوماً فقط، وهو أقصى حد يسمح به القانون. ويتابعون بعدها مسار النمو المتقدم عن طريق مطالعة فحوصات الحمل والأجنة التي يتم التبرع بها للأبحاث.
إذ قال روبين لوفيل-بادج، رئيس قسم بيولوجيا الخلايا الجذعية وعلم الوراثة النمائي في معهد فرنسيس كريك بلندن: "تكمن الفكرة في النمذجة الفعلية لنمو الأجنة البشرية العادية باستخدام الخلايا الجذعية، مما سيمنحك قدراً كبيراً من المعلومات حول الكيفية التي يبدأ بها النمو والأخطاء واردة الحدوث، وذلك دون الاضطرار إلى استخدام الأجنة المبكرة في البحث". سبق أن أثبت فريق ماغدالينا، بالتعاون مع فريق منافس من معهد وايزمان للعلوم، أن الخلايا الجذعية للفئران يمكن تحفيزها على تجميع نفسها في تكوينات تشبه الأجنة المبكرة. واحتوت تلك التكوينات على جهاز معوي، والشكل الأولي للدماغ، وقلب نابض.

يُذكر أن التفاصيل الكاملة للعمل الأخير (خلق أجنة بشرية اصطناعية) من مختبر جامعة كامبريدج ومعهد كاليفورنيا للتقنية لم تُنشر في دوريةٍ علمية حتى الآن. لكن ماغدالينا تحدثت خلال خطابها في المؤتمر عن زراعة أجنة لمرحلةٍ تتجاوز ما يعادل 14 يوماً من النمو لدى الجنين الطبيعي.
نموذج غير مكتمل
نمت كل واحد من التكوينات النموذجية باستخدام خلية جذعية جنينية واحدة. وبلغت بداية مرحلة النمو المعروفة باسم "تكوّن المعيدة"، حين يتحول الجنين من مرحلة شريط الخلايا المتصل إلى مرحلة تكوين خطوط خلايا مميزة وبناء محاور الجسم الأساسية. ولا يمتلك الجنين قلباً نابضاً، أو أمعاء، أو شكلاً أولياً للدماغ في هذه المرحلة. لكن النموذج كشف عن وجود الخلايا الإنشائية التي تُعَدُّ سلف خلايا البويضات والحيوانات المنوية.
كما أوضحت ماغدالينا لصحيفة بريطانية قبل خطابها: "يُمثل نموذجنا البشري أول نموذج أجنة بشرية ثُلاثي السلالة يُظهر غشاء السلى، والخلايا الحميمية، والخلايا الأرومية الخاصة بالبويضات والحيوانات المنوية. وهذا نموذج جميل ومُخلّق بالكامل من الخلايا الجذعية الجنينية".
أعمال مخالفة للقانون
يُسلط هذا التطور الضوء على مدى السرعة التي تفوق بها العلم على القانون في هذا المجال. إذ يتحرك العلماء في المملكة المتحدة وغيرها من الدول لصياغة توجيهات طوعية، من أجل تنظيم العمل على الأجنة الاصطناعية. يقول لوفيل-بادج: "إذا كانت النية من هذه النماذج هي أن تكون شديدة الشبه بالأجنة الطبيعية؛ فيجب معاملتها بالأسلوب نفسه نوعاً ما. لكن القوانين الحالية لا تفعل ذلك. ويشعر الناس بالقلق حيال هذا الأمر".

هناك سؤال مهم ينتظر الإجابة، ويتعلق بما إذا كانت تلك التكوينات قادرةً -نظرياً- على النمو والتحول إلى مخلوقات حية أم لا. إذ كشفت التقارير أن الأجنة الاصطناعية من خلايا الفئران بدت شبه مطابقة للأجنة الطبيعية. لكنها لم تنمُ وتتحول إلى حيوانات حية بعد زراعتها في أرحام إناث الفئران.
في أبريل/نيسان الماضي، نجح باحثون من الصين في تخليق أجنة اصطناعية من خلايا القردة، ثم زرعوها في أرحام القردة البالغة. وقد ظهرت علامات الحمل المبكرة على بعض القردة، لكن الحمل لم يستمر لأكثر من بضعة أيام في جميع الحالات. كما ذكر العلماء أنهم لا يعرفون بعدُ ما إذا كان العائق في وجه النمو الأكثر تطوراً يرتبط بمسألة فنية، أم أن الأمر يرتبط بسبب بيولوجي أكثر جوهرية. حيث قال لوفيل-بادج: "من الصعب للغاية الإجابة عن هذا السؤال. وسيكون من العسير تحديد ما إذا كانت هناك مشكلة جوهرية أم أن الأمر فني". ثم أردف أن هذه الاحتمالات المجهولة تزيد أهمية الحاجة إلى تشريعات أكثر صرامة.




